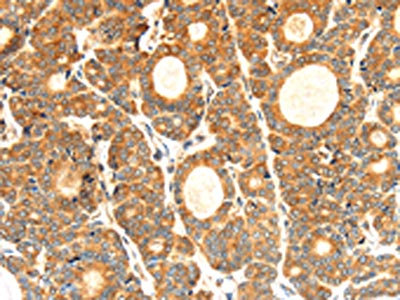

CYP7A1 Antibody
-
中文名稱:CYP7A1兔多克隆抗體
-
貨號:CSB-PA646965
-
規(guī)格:¥3900
-
圖片:
-
The image on the left is immunohistochemistry of paraffin-embedded Human thyroid cancer tissue using CSB-PA646965(CYP7A1 Antibody) at dilution 1/30, on the right is treated with synthetic peptide. (Original magnification: ×200)
-
Gel: 8%SDS-PAGE,Lysate: 40 μg,Lane 1-5: K562 cells, HepG2 cells, Human fetal liver tissue, Human liver cancer tissue, Jurkat cells,Primary antibody: CSB-PA646965(CYP7A1 Antibody) at dilution 1/250 dilution,Secondary antibody: Goat anti rabbit IgG at 1/8000 dilution,Exposure time: 1 minute
-
-
其他:
產(chǎn)品詳情
-
Uniprot No.:
-
基因名:
-
別名:Cholesterol 7 alpha hydroxylase antibody; Cholesterol 7 alpha monooxygenase antibody; Cholesterol 7-alpha-hydroxylase antibody; Cholesterol 7-alpha-monooxygenase antibody; CP7A antibody; CP7A1_HUMAN antibody; CYP 7 antibody; CYP7 antibody; CYP7A1 antibody; CYPVII antibody; Cytochrome P450 7A1 antibody; Cytochrome P450; family 7; subfamily A; polypeptide 1 antibody; Cytochrome P450; subfamily VIIA (cholesterol 7 alpha monooxygenase); antibody; Cytochrome P450; subfamily VIIA (cholesterol 7 alpha-monooxygenase); polypeptide 1 antibody; MGC126826 antibody; MGC138389 antibody
-
宿主:Rabbit
-
反應(yīng)種屬:Human,Mouse
-
免疫原:Synthetic peptide of Human CYP7A1
-
免疫原種屬:Homo sapiens (Human)
-
標(biāo)記方式:Non-conjugated
-
抗體亞型:IgG
-
純化方式:Antigen affinity purification
-
濃度:It differs from different batches. Please contact us to confirm it.
-
保存緩沖液:-20°C, pH7.4 PBS, 0.05% NaN3, 40% Glycerol
-
產(chǎn)品提供形式:Liquid
-
應(yīng)用范圍:ELISA,WB,IHC
-
推薦稀釋比:
Application Recommended Dilution ELISA 1:2000-1:5000 WB 1:500-1:2000 IHC 1:25-1:100 -
Protocols:
-
儲存條件:Upon receipt, store at -20°C or -80°C. Avoid repeated freeze.
-
貨期:Basically, we can dispatch the products out in 1-3 working days after receiving your orders. Delivery time maybe differs from different purchasing way or location, please kindly consult your local distributors for specific delivery time.
-
用途:For Research Use Only. Not for use in diagnostic or therapeutic procedures.
引用文獻(xiàn)
相關(guān)產(chǎn)品
靶點詳情
-
功能:A cytochrome P450 monooxygenase involved in the metabolism of endogenous cholesterol and its oxygenated derivatives (oxysterols). Mechanistically, uses molecular oxygen inserting one oxygen atom into a substrate, and reducing the second into a water molecule, with two electrons provided by NADPH via cytochrome P450 reductase (CPR; NADPH-ferrihemoprotein reductase). Functions as a critical regulatory enzyme of bile acid biosynthesis and cholesterol homeostasis. Catalyzes the hydroxylation of carbon hydrogen bond at 7-alpha position of cholesterol, a rate-limiting step in cholesterol catabolism and bile acid biosynthesis. 7-alpha hydroxylates several oxysterols, including 4beta-hydroxycholesterol and 24-hydroxycholesterol. Catalyzes the oxidation of the 7,8 double bond of 7-dehydrocholesterol and lathosterol with direct and predominant formation of the 7-keto derivatives.
-
基因功能參考文獻(xiàn):
- miR-17 is a novel regulator of CYP7A1 signaling in hepatic lipid metabolism, by which miR-17 may mediate hepatosteatosis. PMID: 29721023
- Rev-erbalpha regulates Cyp7a1 and cholesterol metabolism through its repression of the Lrh-1 receptor. PMID: 29237721
- The analysis of the relationship of polymorphic variants CYP7A1 to lipid metabolic disturbances makes it possible to consider the AA homozygous genotype of variant mutation CYP7A1 rs 38088607 as protective against Dyslipidemia. PMID: 29171472
- Genetic polymorphisms of CYP7A1 may be associated with susceptibility to anti-tuberculosis drug-induced hepatotoxicity in the Chinese population PMID: 27155186
- The pronounced TC reduction in G allele carriers of rs3808607 observed in the previous study may be due to enhanced bile acid synthesis in response to high-viscosity beta-glucan consumption in those individuals. PMID: 29115200
- Current studies suggest that increased Cyp7a1 expression and bile acid synthesis ameliorate hepatic inflammation through activation of FXR PMID: 27534992
- This study provides evidence that individuals carrying the G allele of CYP7A1 single nucleotide polymorphism are more responsive to high molecular weight beta-glucan's effect of lowering circulating cholesterol concentrations than individuals homozygous for the T allele. PMID: 26936139
- Genetic variations in ABCG5, CYP7A1, and DHCR7 may contribute to differing responses of serum cholesterol to dairy intake among healthy adults. PMID: 27052530
- The promoter polymorphism of the CYP7A1 gene has a pronounced impact on diurnal variation in CYP7A1 activity. PMID: 27106353
- The finding that overexpression of HIF-1alpha increased the activity of the CYP7A1 promoter suggested that hypoxia decreased the expression of CYP7A1 in a HIF-1-independent manner. PMID: 26521940
- Macrophage cholesterol efflux in patients with type II diabetes mellitus was significantly reduced, and that this reduction was associated with the down-regulation of CYP7A1 expression. PMID: 26345803
- CYP7A1 and APOE isoform are associated with the extent of reduction in circulating LDL cholesterol in response to plant sterols consumption. PMID: 26333513
- The CYP7A1 rs7833904 polymorphism may modify the risk of CAD. PMID: 25944972
- The CYP7A1 crystallographic models identify residues involved in cholest-4-en-3-one binding. PMID: 24927729
- genetic polymorphism is associated with the total cholesterol level and the lipid-lowering efficacy of statin treatment. [meta-analysis] PMID: 25499945
- we identified for the first time a significant association of the A-204C polymorphism of the CYP7A1 gene and development of tuberculosis in a Moroccan population PMID: 25360185
- The CYP7A1 -204A>C polymorphism is significantly associated with serum lipid levels in Asian population, but not gallbladder stone disease. [Meta-analysis] PMID: 25103562
- Cyp7a1 is a direct Thyroid hormone receptor (TR) target gene that responds to physiologic TR levels through a set of distinct response elements in its promoter. PMID: 24582860
- Activation of the VDR represses hepatic SHP to increase levels of CYP7A1 and reduce cholesterol. PMID: 24365583
- Two known single nucleotide polymorphisms were identified in the 5'-UTR of CYP7A1 and both were associated with neuromyelitis optica but not with Multiple sclerosis. PMID: 23740208
- Genetic variants of CYP7A1 and its transcriptional activators (HNF4A and PPARGC1A) may activate bile acid synthesis, resulting in the accumulation of bile acids in hepatocytes leading primary biliary cirrhosis progression. PMID: 23354620
- Prox1 interacts with LSD1 to recruit the repressive LSD1/NuRD complex to CYP7A1 promoter and co-represses transcription through epigenetic mechanisms. PMID: 23626788
- A variant of COUP-TFII downregulates the function of COUP-TFII by inhibiting its binding to DNA, decreasing Cyp7a1 expression. PMID: 23458092
- HNF4alpha and LRH-1 promote active transcription histone marks on the Cyp7a1 promoter that are reversed by FGF19 in a SHP-dependent manner PMID: 23038264
- Liver X receptor alpha is required for induction of trascription of CYP7A1 in response to resveratrol. PMID: 22607622
- these data suggest that FGF7 is a novel regulator of CYP7A1 expression in hepatocytes and may prevent hepatocytes from accumulating toxic bile acids during liver injury and fibrosis. PMID: 22713451
- gender, but not SLCO1B1 or CYP7A1 polymorphism, has a major effect on the fasting plasma concentrations of individual bile acids PMID: 21902813
- CYP7A1 polymorphisms are associated with colorectal adenoma. PMID: 22058145
- The main enzyme regulating bile acids biosynthesis is CYP7A1 (7alpha-cholesterol hydroxylase). [review] PMID: 22235657
- 7-dehydrocholesterol (the immediate precursor of cholesterol) is oxidized by P450 7A1 to 7-ketocholesterol. PMID: 21813643
- The frequencies of rs3808607 alleles in the CYP7A1 gene differed significantly between obese hypertensive and normotensive men. PMID: 21346769
- Results suggest that promoter -204A > C variant is associated with enhanced CYP7A1 activity. PMID: 20884100
- Cytochrome P450 7A1 cholesterol 7alpha-hydroxylation: individual reaction steps in the catalytic cycle and rate-limiting ferric iron reduction. PMID: 21147774
- The mRNA expression levels of sodium taurocholate cotransporting polypeptide, bile salt export pump, and hepatic cholesterol 7alpha-hydroxylase were significantly higher in the primary biliary cirrhosis patients than in the controls. PMID: 20857261
- These results demonstrate that no association exists between apoB-100, apoE, and CYP7A1 polymorphisms and cholelithiasis in a Mexican population. PMID: 20872969
- study found glucose positively regulated hepatocyte CYP7A1 gene & bile acid synthesis; this glucose-mediated induction of CYP7A1 transcription may be mediated by both AMPK-dependent pathway & epigenetic regulation of CYP7A1 chromatin structure PMID: 19965590
- miR-122a and miR-422a may destabilize CYP7A1 mRNA to inhibit CYP7A1 expression. PMID: 20351063
- insulin is involved in the regulation of diurnal variation of CYP7A1 activity in humans PMID: 19537927
- Statistical analyses revealed that a common promoter SNP in CYP7A1 has a protective/gene dose-dependent effect on the risk of NMO. PMID: 19850125
- mechanism for gallbladder cancer susceptibility by CYP7A1 haplotype appears to be independent of gallstone pathway and is believed to involve genotoxicity resulting from subnormal bile acid production PMID: 20005541
- The study provides evidence that -278A>C polymorphism in the CYP7A1 gene can modify triglyceride concentrations in response to a reduced fat diet in a dyslipidemic male population. PMID: 19448895
- CYP7A1 regulates the pathway through which cholesterol is converted into bile acids. PMID: 11907135
- regulation of CYP7A1 and CYP27A1 in human liver PMID: 12011083
- Human CYP7A1 deficiency: progress and enigmas. Review. PMID: 12093884
- New metabolic disorder presenting with hyperlipidemia caused by a homozygous deletion mutation in CYP7A1. PMID: 12093894
- data suggest that the lack of an LXR element in the region from -56 to -49 of the human CYP7A1 promoter may account for some of the differences in response to diets between humans and rodents PMID: 12202481
- characterization of the coordinated regulation of cholesterol metabolism in human liver; regulation of its mRNA in liver PMID: 12213890
- Data reveal a fundamental difference in the regulation of CYP7A1 in rodent and human hepatocytes. PMID: 12554795
- demonstrated that FGF-19, acting as an FXR-induced signaling molecule, represses expression of the CYP7A1 gene; this signaling cascade defines a novel mechanism for feedback repression of bile acid biosynthesis PMID: 12815072
- bile acids suppress transcription of the gene (CYP7A1) encoding cholesterol 7alpha-hydroxylase, the rate-limiting enzyme in bile acid biosynthesis PMID: 12865425
顯示更多
收起更多
-
亞細(xì)胞定位:Endoplasmic reticulum membrane; Single-pass membrane protein. Microsome membrane; Single-pass membrane protein.
-
蛋白家族:Cytochrome P450 family
-
組織特異性:Detected in liver.
-
數(shù)據(jù)庫鏈接:
Most popular with customers
-
-
YWHAB Recombinant Monoclonal Antibody
Applications: ELISA, WB, IHC, IF, FC
Species Reactivity: Human, Mouse, Rat
-
Phospho-YAP1 (S127) Recombinant Monoclonal Antibody
Applications: ELISA, WB, IHC
Species Reactivity: Human
-
-
-
-
-